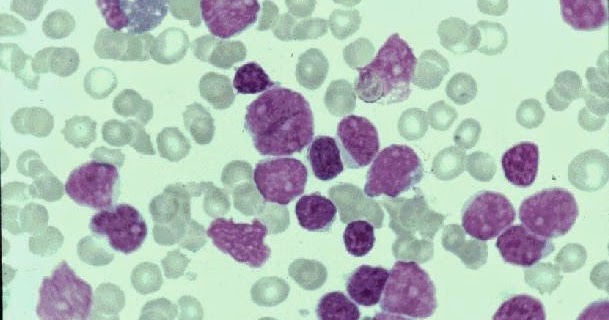
HEMATOLOGIA LINFOMA DE CÉLULAS DEL MANTO

El linfoma de células del manto es un tipo de cáncer del sistema linfático por proliferación desordenada de linfocitos B transformados en células malignas. Se clasifica como una de las variantes del linfoma no Hodgkin de células B. Debe su nombre a que se origina en la región del manto de los ganglios linfáticos. Se inicia por el aumento de tamaño de un ganglio linfático, posteriormente la enfermedad puede diseminarse e invadir otros órganos, entre ellos médula ósea, hígado, intestino, piel, pulmón y sistema nervioso central. [1] La supervivencia media se estima cercana a los 6 años para los pacientes nuevos. Las células de este tipo de linfoma sobreexpresan la proteína ciclina D1 debido a la translocación cromosómica t(11;14)(q13;q32), que afecta a los genes BCL1 e IgH.
Epidemiología
Representa aproximadament el 4% por de los casos de linfoma y el 6% de los casos de linfoma no Hodgkin. Es más frecuente en hombres que en mujeres con una razón de entre dos y cuatro hombres por cada mujer. La edad media de aparición son 65 años.[1]
Etiología
La traslocación t(11;14)(q13;q32) es la causa de la sobreexpresión de la proteína ciclina D1, la cual estimula el proceso de división celular dando origen al linfoma. La ciclina D1 altera el control celular que gobierna la supresión de genes tumorales favoreciendo la expansión del tumor.[2]
Síntomas
Los síntomas principales son: fiebre, sudoración nocturna, pérdida de peso, aumento de tamaño de los ganglios linfáticos y esplenomegalia. Algunos pacientes pueden presentar una forma leucémica que imita una leucemia aguda. En ocasiones aparece una poliposis linfomatoide con múltiples pólipos linfoides en intestino delgado e intestino grueso. [3]
Diagnóstico
El diagnóstico se basa en tomar una biopsia del tejido afectado, por lo general de un ganglio linfático, y realizar un análisis de la muestra mediante el microscopio por un médico especializado en anatomía patológica. Para determinar si existe extensión a otros órganos pueden realizarse estudios de imagen mediante tomografía axial computarizada o resonancia magnética nuclear de tórax, abdomen y pelvis. En algunos pacientes se realiza punción lumbar para evaluar el líquido cefalorraquídeo y colonoscopia por si existe afectación del colon. La tomografía por emisión de positrones o PET del cuerpo entero permite evaluar la extensión del linfoma y la respuesta al tratamiento.
Pronóstico
El pronóstico de la enfermedad depende de numerosos factores, entre ellos la edad, el estado funcional y la extensión del proceso. Alrededor del 70% de los pacientes presentan la enfermedad en un estadio avanzado en el momento del diagnóstico. En algunos casos el linfoma invaden la médula ósea y la sangre periférica, lo cual empeora el pronóstico.
Tratamientos
Diferentes regímenes de tratamiento están disponibles y consiguen a menudo buenas tasas de respuesta, pero los pacientes tienden a presentar recaídas que son más difíciles de tratar. Se logra la remisión completa en entre el 10% y el 60% de los casos, produciéndose la recaída después de entre 12 y 28 meses.[4] En esencia existen cuatro tipos de tratamientos actualmente en uso general: quimioterapia, inmunoterapia, radioimmunoterapia y terapias dirigidas. El régimen terapéutico más empleado se basa en la admistración de antraciclina, rituximab, ciclofosfamida, doxorrubicina, vincristina y prednisona.
Quimioterapia
Los tratamientos de quimioterapia se utilizan extensamente. Para el primer tratamiento, CHOP (ciclofosfamida, doxorrubicina, vincristina, prednisona) es la quimioterapia más común.[5]
Inmunoterapia
El rituximab es un anticuerpo monoclonal que puede tener buena actividad contra la enfermedad, especialmente si se utiliza conjuntamente con quimioterapia para prolongar la duración de respuesta. Rituximab se une específicamente al antígeno CD20, una fosfoproteína transmembrana no glucosilada de los linfocitos pre-B y B maduros que se sobrexpresa en más del 95 % de los linfomas no hodgkinianos de linfocitos B.
Radioinmmunoterapia
Anticuerpos monoclonales combinados con moléculas radiactivas son conocidas como radioimmunoterapia. Estos compuestos incluyen itrio90-ibritumomab tiuxetan y yodo131 tositumomab (Bexxar).
Terapia dirigida
La mayor parte de los fármacos de este grupo funcionan bloqueando la acción de proteínas específicas que estimulan la formación y la diseminación de los tumores. Existen cuatro fármacos de este grupo (bortezomib, temsirolimus, lenalidomida e ibrutinib) que han demostrado mejorar significativamente el pronóstico. Estos fármacos se han aprobado por la Agencia Europea de Medicamentos y por la Administración de Alimentos y Medicamentos de Estados Unidos (FDA) para el tratamiento de pacientes con enfermedad recidivante y/o refractaria. El bortezomib también ha sido aprobado para pacientes no tratados previamente.[6]
Otros
Trasplante autólogo de células madre hematopoyéticas. El autotrasplante de células madre se realiza recogiendo las células madre del propio paciente que se congelan y se devuelven al paciente después de administrarle dosis elevadas de quimioterapia.
Terapia CAR-T. Brexucabtagene autoleucel está indicado en el linfoma de células del manto y en leucemia linfoblástica aguda.[7]
Referencias
:max_bytes(150000):strip_icc()/mantle-cell-lymphoma-2252374.FINAL-707f1cf1baa34d4991f27b99e48536a4.gif)

![]()